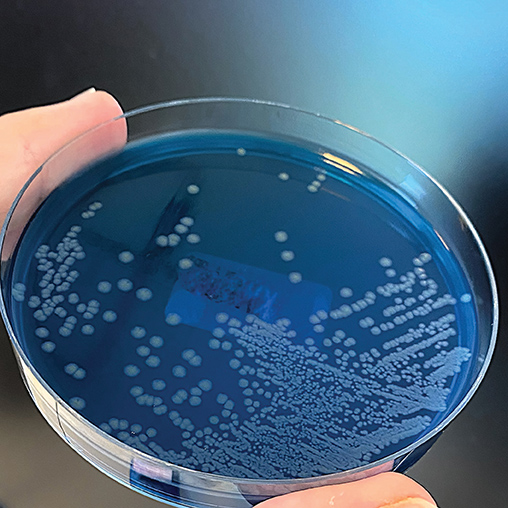

Biotechnology applications are expanding globally into many areas beyond the pharmaceutical sector. A growing range of products meet consumer demands while contributing to sustainability and climate protection. However, the current European authorization process for these innovative products is unnecessarily burdensome and limits market access. Leading European business organizations have come together in the European Biosolutions Coalition to change this.

Jan Lucht
scienceindustries | Head Biotechnology
The Life Sciences and Biotechnology sector is a central pillar for the Swiss economy. Healthcare products, including therapeutic proteins and vaccines, comprise the most important export category. However, food and feed additives, flavors and fragrances also play important roles (see Swiss Exports article, Page 14), and applications of biotechnology are rapidly expanding into different fields.
Well over 90% of scienceindustries’ member companies’ sales are generated abroad. For this reason, favorable market conditions in export markets are of key importance to the Swiss life sciences industry.
Biological industrial solutions from outside the pharmaceutical sector - biosolutions for short - make use of nature’s tools such as enzymes, microorganisms and fermentation, often enhanced by modern biotechnology, to produce goods and services. Applications include biobased alternatives to fossil-based materials, food and feed ingredients, alternative proteins, biological crop protection products and efficient recycling technologies.
Biosolutions meet consumer demands and have huge potential for climate and resource protection, sustainability, innovation and competitiveness. Scaling up the implementation of existing biosolution technologies could make a significant contribution to achieving the goal of net-zero greenhouse gas emissions. At the same time, more efficient food production could support feeding the growing global population while saving valuable agricultural land and preserving limited natural resources and biodiversity. Waste and environmental impact could be minimized, and bio-based supply chains could contribute to a circular, more sustainable economy and the creation of new jobs. Unfortunately, the regulatory environment for novel biosolutions often delays or hinders the realization of their potential in Europe.
Optimizing the protection of crops against diseases to ensure yields and product quality requires a broad toolbox. Increasingly, nature-based biocontrol agents are playing a key role as part of an integrated pest management strategy. In collaboration, Switzerland-based company Syngenta developed and is distributing the biofungicide TAEGRO® which consists of endospores from a specific bacterial strain that are activated when mixed with water. TAEGRO’s modes of action present a remarkably low risk of resistance development and, when used together with conventional products, it increases efficacy by 20% in most crops.
Bio-based TAEGRO is harmless for beneficial insects, pollinators and humans, and ensures healthy yields while reducing chemical usage. However, as the approval processes in Europe are focused on conventional chemical plant protection products, it took eight years for TAEGRO to enter European markets, whereas registration in other key markets typically takes two to three years.
Human milk oligosaccharides (HMOs) are a mixture of complex sugar molecules that are the third most abundant component of breast milk. They contribute to infant development, and to the establishment of a healthy gut microbiome and a resilient immune system. In cases when breastfeeding is not possible or no longer desired, HMOs can be added to infant formula to make it as similar as possible to human milk. There is no alternative natural source for HMOs, and chemical synthesis is complex and expensive.

The Swiss-Dutch company, dsm-firmenich, uses precision fermentation, a biotechnological process with metabolically adapted microorganisms and renewable feedstocks, to produce HMOs in an affordable and more sustainable way on an industrial scale. The “novel food” authorization process for innovative foods in Europe is very complex and can take up to 3 to 5 years – much longer than in most other world regions. Additionally, the regulations for foods produced using modern biotechnology can be subject to varying interpretations, which can complicate market access and sales.
As European regulatory processes frequently operate within outdated frameworks that are not adapted to innovative production technologies, obtaining product approvals is often a time-consuming process that is much slower than in other regions of the world. In addition, there are often high bureaucratic hurdles to overcome.
This is particularly problematic for smaller companies with limited resources. In some cases, promising European inventions from outside the pharmaceutical sector are therefore first brought to market in regions with more proportionate and more innovationfriendly regulatory approval processes. Europe loses out on the commercial and competitive potential of these products, their availability to consumers here and, last but not least, the sustainability benefits they offer.
In order to strengthen Europe’s sustainability, resilience and competitiveness by promoting better access to biosolutions for European customers, in October 2023 five leading European business organizations joined forces to form the European Biosolutions Alliance (www.eubiocoalition.eu). Switzerland was one of the founding members and is represented by the umbrella business organization, economiesuisse. It works closely with scienceindustries, the Swiss association of the chemical, pharmaceutical and life sciences industries. By the end of 2024, the coalition had grown to 11 European business organizations.
The European Biosolutions Coalition has been established to support the development of enabling framework conditions for biosolutions in Europe. This includes the removal of legislative barriers and outdated regulations that hinder their potential, and the streamlining of the authorization process for biosolutions in the EU. Europe already boasts an excellent R&D ecosystem and a host of innovative companies from the biotechnology and biomanufacturing field with many promising biosolutions – now is the time to facilitate their introduction in European markets to reap their economic and environmental benefits here. The relevance of biosolutions for Europe’s competitiveness and sustainability is illustrated by a showcase collection of biosolutions from different European countries, including Switzerland.
The development of new European policy frameworks, such as the Biotech Act announced by European Commission President Ursula von der Leyen in 2024 and expected to be finalized in 2026, offers significant opportunities. By developing key policy objectives and working with stakeholders including European policy makers and regulatory authorities, the European Biosolutions Coalition strives for a bold, cross-sectoral Biotech Act. In this, they closely collaborate with other leading industry associations such as EuropaBio. For Switzerland, the powerful international alliance with the European Biosolutions Coalition offers the chance to support favorable conditions in a key export market, but also to use positive developments in other European countries as a blueprint to improve the framework conditions for innovative biosolutions at home.